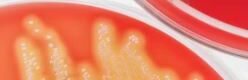

Session Purpose:
To explore how understanding bacterial quorum sensing can lead to innovative strategies for combating antimicrobial resistance.
Key Objectives:
Explain the mechanisms and significance of quorum sensing in bacterial communication.
Discuss how quorum sensing influences infection, virulence, and biofilm formation.
Highlight emerging approaches targeting quorum sensing pathways for antimicrobial development.
Speaker: Silas Onyango Awuor – MLO, Jaramogi Oginga Odinga Teaching and Referral Hospital Role: Diagnosis
Moderator: Ms. Susan Kiambi—Maabara Online
CPD Points: This event is worth 3 CPD points
N/B:
i) The minimum duration for participation to qualify for CPD points is 60%.
ii) Use the same email address used during registration to join the meeting.
iii) Ensure the details used during registration are correct.
iv) Your CPD points will be uploaded on your KMLTTB CPD portals after the event and within 24 hours.
v) Registration closes at 7:45 PM before the next event.
- Organizer Name: Maabara Online
- Phone: 0758978931
- Email: maabarahub@gmail.com
- Website: https://maabaraonline.com
